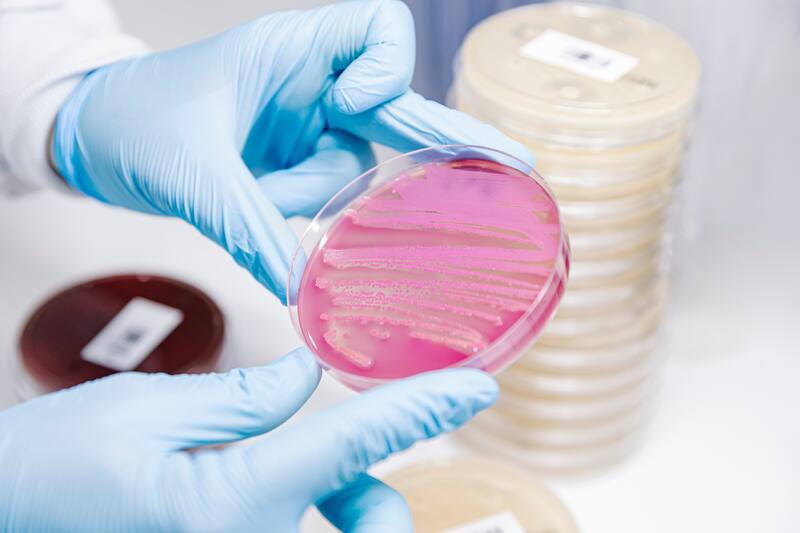

Por Constanza FernándezPor esta razón no debes dejar el celular en la cama: no se relaciona con fallas técnicas
Las personas usan su celular durante todo el día y al acostarse lo llevan consigo, lo que muchos no saben es que esto puede ser realmente peligroso.

Los celulares se han convertido casi en una extensión de nuestro brazo y es que los llevamos con nosotros a todas partes, incluso a la hora de acostarse.
Según reveló un estudio realizado por Mattress Next Day, dejar el celular en la cama no solo afecta el descanso, sino también nuestra salud y la vida útil del dispositivo.
Los científicos analizaron la presencia de bacterias en teléfonos y relojes inteligentes y para sorpresa de muchos, encontraron altas cantidades de gérmenes.
BACTERIAS EN LA CAMA
El estudio detectó la presencia de una bacteria llamada Pseudomonas aeruginosa, aunque generalmente es inofensiva para personas sanas, puede provocar irritaciones cutáneas, infecciones respiratorias y, en casos más graves, sepsis.
Según señalan, la bacteria tiene la capacidad de reproducirse en ambientes cálidos y húmedos, como las sábanas y almohadas donde muchos suelen colocar sus celulares al dormir.
Para evitar la propagación de las bacterias, los expertos que trabajaron en el estudio, revelaron una serie de medidas preventivas que buscan beneficiar tanto a la salud de las personas como al dispositivo:
- Limpiar el celular al menos una vez al día con paños desinfectantes o alcohol isopropílico para eliminar bacterias.
- Intentar no llevar el celular ni otros dispositivos a la cama. Si es imprescindible colocarlo sobre una mesita o cualquier superficie alejada del contacto directo con las sábanas.
- Utilizar una funda y un protector de pantalla puede ayudar a reducir la cantidad de gérmenes que se acumulan en la superficie del dispositivo.
- Lavarse las manos antes de usar el celular y evitar llevarlo a lugares propensos a la acumulación de gérmenes, como baños o cocinas.
Imperdibles
Lo último
04:00
00:32
00:01
01:51
23:29
Lo más leído
2.
3.
4.

















